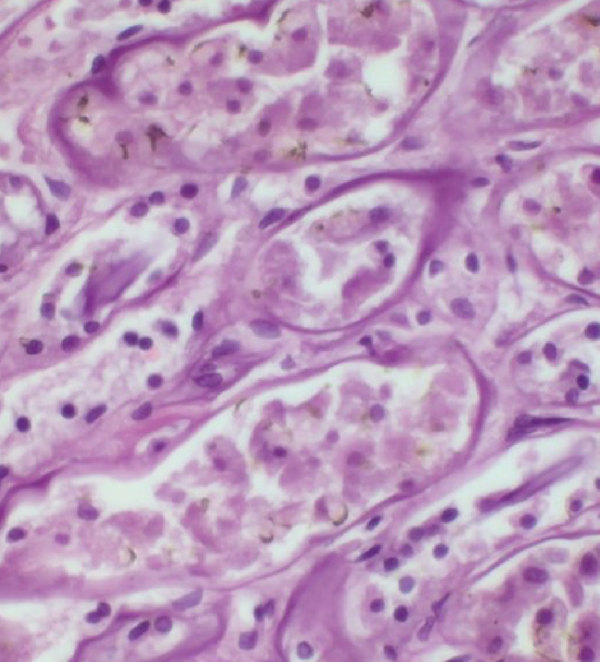
Application-2.jpg

Custom solutions
Pushing the Limits of Imaging Technology for Advanced Metrology
Prodrive Technologies has a strong track record in developing advanced imaging solutions for metrology applications across the semiconductor, flat panel display and life science industries. In these fields, we excel by delivering an optimized combination of pixel resolution, speed, and sensitivity across multiple domains including E-beam, DUV, visible light, X-ray, and Terahertz imaging.
Domain expertise
Our strength lies in collaboration with industry leaders to craft tailored imaging solutions. The multidisciplinary nature of Prodrive Technologies allows us to assemble design teams to work closely together with customers and evaluate technical challenges from a system perspective. This will result in the best technical approach for each unique challenge. The solutions we develop are typically primed for long-term production of more than 10 years. To ensure every design is optimized for mass production we already involve manufacturing architects at an early stage in a design project.
From Sensor design to Camera
For the camera solutions we develop, off-the-shelf sensors often fall short. For this reason, our cameras are designed to utilize custom sensors tailored to excel on resolution, sensitivity and pixelrate for a specific application. These sensors are developed within our design-house partner network, where our engineering teams engage early in the process to ensure optimal design decisions that directly benefit the camera architecture later on. Prodrive facilitates this with in-house ISO5 cleanrooms, including a BEOL facility for custom sensor integration. This allows us to take full responsibility for the entire process — from sensor design to final camera assembly. Our true end-to-end approach reduces project complexity and accelerates time-to-market for our customers.
We understand Fab Equipment
Prodrive designs fully customized cameras in close collaboration with our customers. Our multi-disciplinary engineering teams acts as true partners, translating complex equipment requirements into precise camera specifications. Built for high-performance semiconductor and life-science applications, our cameras are engineered to excel under extreme conditions — from ultra-high vacuum environments to active water-cooling systems — while maintaining the thermal stability demanded by next-generation metrology tools. We understand reliability is key in fab equipment and that’s why all Prodrive camera products feature real-time diagnostics of a very broad set of parameters.
End-to-End Proposition
We provide fully custom-developed imaging systems for applications with the most stringent requirements—where off-the-shelf cameras and sensors fall short.
Our end-to-end approach sets us apart:
We design and manufacture cameras around custom imaging sensors that achieve the perfect balance of resolution, speed, and sensitivity. Our design teams support sensor design houses in design choices that enable a smooth integration during the camera design process. Our manufacturing services cover the whole process “from Wafer to Camera”. This includes probing and dicing of finished wafers into sensors and the integration of these sensors into a camera.
Prodrive is vertically integrated offering includes high- bandwidth cameras and data processing solutions to enable real-time processing of the enormous amounts of measurement data generated by today's metrology equipment. This holistic approach empowers our customers to realize next- generation imaging systems that deliver unmatched performance and reliability.
Prodrive Technologies has a strong track record in developing advanced imaging solutions for metrology applications across the semiconductor, flat panel display and life science industries. In these fields, we excel by delivering an optimized combination of pixel resolution, speed, and sensitivity across multiple domains including E-beam, DUV, visible light, X-ray, and Terahertz imaging.
Domain expertise
Our strength lies in collaboration with industry leaders to craft tailored imaging solutions. The multidisciplinary nature of Prodrive Technologies allows us to assemble design teams to work closely together with customers and evaluate technical challenges from a system perspective. This will result in the best technical approach for each unique challenge. The solutions we develop are typically primed for long-term production of more than 10 years. To ensure every design is optimized for mass production we already involve manufacturing architects at an early stage in a design project.
From Sensor design to Camera
For the camera solutions we develop, off-the-shelf sensors often fall short. For this reason, our cameras are designed to utilize custom sensors tailored to excel on resolution, sensitivity and pixelrate for a specific application. These sensors are developed within our design-house partner network, where our engineering teams engage early in the process to ensure optimal design decisions that directly benefit the camera architecture later on. Prodrive facilitates this with in-house ISO5 cleanrooms, including a BEOL facility for custom sensor integration. This allows us to take full responsibility for the entire process — from sensor design to final camera assembly. Our true end-to-end approach reduces project complexity and accelerates time-to-market for our customers.
We understand Fab Equipment
Prodrive designs fully customized cameras in close collaboration with our customers. Our multi-disciplinary engineering teams acts as true partners, translating complex equipment requirements into precise camera specifications. Built for high-performance semiconductor and life-science applications, our cameras are engineered to excel under extreme conditions — from ultra-high vacuum environments to active water-cooling systems — while maintaining the thermal stability demanded by next-generation metrology tools. We understand reliability is key in fab equipment and that’s why all Prodrive camera products feature real-time diagnostics of a very broad set of parameters.
End-to-End Proposition
We provide fully custom-developed imaging systems for applications with the most stringent requirements—where off-the-shelf cameras and sensors fall short.
Our end-to-end approach sets us apart:
We design and manufacture cameras around custom imaging sensors that achieve the perfect balance of resolution, speed, and sensitivity. Our design teams support sensor design houses in design choices that enable a smooth integration during the camera design process. Our manufacturing services cover the whole process “from Wafer to Camera”. This includes probing and dicing of finished wafers into sensors and the integration of these sensors into a camera.
Prodrive is vertically integrated offering includes high- bandwidth cameras and data processing solutions to enable real-time processing of the enormous amounts of measurement data generated by today's metrology equipment. This holistic approach empowers our customers to realize next- generation imaging systems that deliver unmatched performance and reliability.

Mastering design challenges
- - Our solutions extend far beyond conventional off-the-shelf designs. We tackle complex challenges to help our customers achieve breakthrough performance, including:
- - Design and Integration of (large) custom sensors
- - Development of ultra–high-bandwidth electronics (typically 50 – 500 Gbps) within compact mechanical constraints
- - Implementation of active and passive cooling solutions for operation below 0°C even in ultra-high vacuum environments
- - Designs and manufacturing compliant with ultra-high vacuum conditions (to 1e-9 mbar and beyond)
- - Integration of onboard processing to reduce computational load on the host system
- - Designing for long lifetimes, typically 10+ years
Benefits
Application areas
Our TDI camera covers a wide field of applications including multi-electron beam, X-ray, DUV, visible light, and infrared imaging
-
DNA sequencing

-
Flat panel display processing

-
PCB inspection

-
Digital pathology
-
Wafer inspection

Markets
-
Semiconductor

Image processing and defect classification
-
Medical & life sciences

Video-over-IP solution for low-latency, uncompressed video distribution
-
Flat panel display

Components and solutions for LED, LCD, DLP, plasma and LCD displays
Technical specifications

